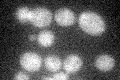
YDL159W

View description
Signal transducing MAP kinase kinase involved in pheromone response, where it phosphorylates Fus3p, and in the pseudohyphal/invasive growth pathway, through phosphorylation of Kss1p; phosphorylated by Ste11p, degraded by ubiquitin pathway
Localization:
Intensity:
Fold change:
Significance:
-
C’ GFP library in SD
cytosol23.81 -
N' NOP1pr-GFP in SD

cytosol,bud56.8823 -
N' TEF2pr-mCherry in SD

cytosol,bud23.4987 -
N' NATIVEpr-GFP in SD

below threshold26.7434 -
N' TEF2pr-VC and Cyto-VN in SD

cytosol37.4272 -
C’ GFP library in SD+DTT

cytosol33.311.39Yes -
C’ GFP library in SD+H2O2

cytosol25.251.06No -
C’ GFP library in Starvation Media

cytosol21.830.91No -
C’ GFP library on the background of Pup2-DaMP

cytosol -
C’ GFP library on the background of CCT mutant

cytosol26.18481.0996No
